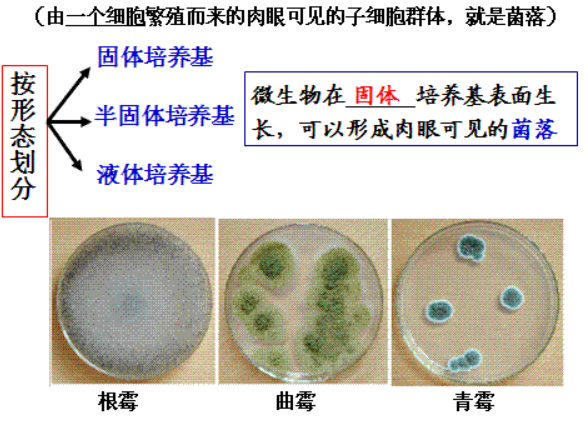
多主枝孢(蜡叶芽枝霉)

万千商家帮你免费找货
0 人在求购买到急需产品
- 详细信息
- 技术资料
- 库存:
100
- 英文名:
Cladosporium herbarum(Persoon)LinketFries
- 保质期:
详询
- 供应商:
上海晅科生物科技有限公司
- 保存条件:
2-8℃
- 规格:
冻干粉/菌液
以下是多主枝孢(蜡叶芽枝霉)的订购信息:
菌种名称:多主枝孢(蜡叶芽枝霉)
拉丁学名:Cladosporium herbarum(Persoon)LinketFries
提供形式:冻干粉;斜面;菌液;平板
储存条件:培养物和冻干菌种应在 2~8℃保存,勿长期置于室温。
有效期:6 年
活化步骤: ①准备上述平板 1-2 块;②安瓿管表面消毒后在安全柜中打开, 用酒精灯灼烧顶部,后迅速滴上无菌水使之破裂,随后用镊子 将其敲碎;③吸取 0.5mL 无菌水(置于厌氧环境平衡 24h)打入冻干管,充分溶解菌粉后,打入平板中 200μL/个,涂布均匀; ④将平板置于上述培养条件下培养,7-10 天。

多主枝孢(蜡叶芽枝霉)注意事项:
1、请务必了解培养微生物需要注意的安全事项,默认由微生物专业技术人员操作;
2、建议严格按照 培养说明来操作,认真阅读说明,尤其是要点提示部分,并记录好菌种编号和菌种制作日期(批号);
3、使用前,认真阅读并理解随货的“菌种培养说明”和“开管说明”如有任何疑问,请于操作前咨询我司。
4、如若有菌种复苏不活或污染等情况,请在收到菌种后1个月内联系我司,逾期将不予受理。
菌种保藏是指保持微生物菌株的活力和遗传性状的技术。微生物在使用和传代过程中容易发生污染、变异甚至死亡,因而常常造成菌种的衰退。菌种保藏的目的就是使菌株存活、不丢失、不污染杂菌、不发生或少发生变异,保持菌种原有的活性和各种特征。菌种保藏的基本原理是使微生物的生命活动处于半永久性的休眠状态,也就是将微生物的新陈代谢作用限制在最低范围内。
菌种名称:多主枝孢(蜡叶芽枝霉)
拉丁学名:Cladosporium herbarum(Persoon)LinketFries
提供形式:冻干粉;斜面;菌液;平板
储存条件:培养物和冻干菌种应在 2~8℃保存,勿长期置于室温。
有效期:6 年
活化步骤: ①准备上述平板 1-2 块;②安瓿管表面消毒后在安全柜中打开, 用酒精灯灼烧顶部,后迅速滴上无菌水使之破裂,随后用镊子 将其敲碎;③吸取 0.5mL 无菌水(置于厌氧环境平衡 24h)打入冻干管,充分溶解菌粉后,打入平板中 200μL/个,涂布均匀; ④将平板置于上述培养条件下培养,7-10 天。
多主枝孢(蜡叶芽枝霉)注意事项:
1、请务必了解培养微生物需要注意的安全事项,默认由微生物专业技术人员操作;
2、建议严格按照 培养说明来操作,认真阅读说明,尤其是要点提示部分,并记录好菌种编号和菌种制作日期(批号);
3、使用前,认真阅读并理解随货的“菌种培养说明”和“开管说明”如有任何疑问,请于操作前咨询我司。
4、如若有菌种复苏不活或污染等情况,请在收到菌种后1个月内联系我司,逾期将不予受理。
菌种保藏是指保持微生物菌株的活力和遗传性状的技术。微生物在使用和传代过程中容易发生污染、变异甚至死亡,因而常常造成菌种的衰退。菌种保藏的目的就是使菌株存活、不丢失、不污染杂菌、不发生或少发生变异,保持菌种原有的活性和各种特征。菌种保藏的基本原理是使微生物的生命活动处于半永久性的休眠状态,也就是将微生物的新陈代谢作用限制在最低范围内。
实验室常用的保菌方法有:甘油保菌法、斜面保菌法、穿刺保菌法、液体石蜡覆盖保藏法、沙土保藏法、冷冻干燥法。微基生物在以上几种菌种保藏方法的基础上,开发出了保菌效果更好瓷珠保菌法。

| 博伊丁假丝酵母 | Candida boidinii | 冻干粉;斜面;菌液;平板 |
| 博伊丁假丝酵母 | Candida boidinii | 冻干粉;斜面;菌液;平板 |
| 酿酒酵母 | Saccharomyces cerevisiae | 冻干粉;斜面;菌液;平板 |
| 热带假丝酵母 | Candida tropicalis | 冻干粉;斜面;菌液;平板 |
| 麦芽糖假丝酵母 | Candida maltosa | 冻干粉;斜面;菌液;平板 |
| 巴斯德酵母 | Saccharomyces pasteurianus | 冻干粉;斜面;菌液;平板 |
| 单孢哈萨克斯坦酵母 | Kazachstania unisporus | 冻干粉;斜面;菌液;平板 |
| 近平滑假丝酵母 | Candida parapsilosis | 冻干粉;斜面;菌液;平板 |
| 东方伊萨酵母 | Issatchenkia orientalis | 冻干粉;斜面;菌液;平板 |
| 博伊丁假丝酵母 | Candida boidinii | 冻干粉;斜面;菌液;平板 |
| 葡萄牙棒孢酵母 | Clavispora lusitaniae | 冻干粉;斜面;菌液;平板 |
| 东方伊萨酵母 | Issatchenkia orientalis | 冻干粉;斜面;菌液;平板 |
| 罗伦隐球酵母 | Cryptococcus laurentii | 冻干粉;斜面;菌液;平板 |
| 荚复膜孢酵母 | Saccharomycopsis capsularis | 冻干粉;斜面;菌液;平板 |
| 麦芽糖假丝酵母 | Candida maltosa | 冻干粉;斜面;菌液;平板 |
| 麦芽糖假丝酵母 | Candida maltosa | 冻干粉;斜面;菌液;平板 |
| 伯顿毕赤酵母 | Pichia burtonii | 斜面;菌液;平板 |
| 产朊假丝酵母 | Candida utilis | 冻干粉;斜面;菌液;平板 |
风险提示:丁香通仅作为第三方平台,为商家信息发布提供平台空间。用户咨询产品时请注意保护个人信息及财产安全,合理判断,谨慎选购商品,商家和用户对交易行为负责。对于医疗器械类产品,请先查证核实企业经营资质和医疗器械产品注册证情况。
多主枝孢(蜡叶芽枝霉)
¥300 - 2500










